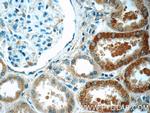
ACSM3 Antibody in Immunohistochemistry (Paraffin) (IHC (P))

Search
Proteintech
ACSM3 Polyclonal Antibody
{{$productOrderCtrl.translations['antibody.pdp.commerceCard.promotion.promotions']}}
{{$productOrderCtrl.translations['antibody.pdp.commerceCard.promotion.viewpromo']}}
{{$productOrderCtrl.translations['antibody.pdp.commerceCard.promotion.promocode']}}: {{promo.promoCode}} {{promo.promoTitle}} {{promo.promoDescription}}. {{$productOrderCtrl.translations['antibody.pdp.commerceCard.promotion.learnmore']}}
产品信息
10168-2-AP
种属反应
已发表种属
宿主/亚型
分类
类型
抗原
偶联物
形式
浓度
规格
纯化类型
保存液
内含物
保存条件
运输条件
产品详细信息
Immunogen sequence: MLARVTRKM LRHAKCFQRL AIFGSVRALH KDNRTATPQN FSNYESMKQD FKLGIPEYFN FAKDVLDQWT DKEKAGKKPS NPAFWWINRN GEEMRWSFEE LGSLSRKFAN ILSEACSLQR GDRVILILPR VPEWWLANVA CLRTGTVLIP GTTQLTQKDI LYRLQSSKAN CIITNDVLAP AVDAVASKCE NLHSKLIVSE NSREGWGNLK ELMKHASDSH TCVKTKHNEI MAIFFTSGTS GYPKMTAHTH SSFGLGLSVN GRFWLDLTPS DVMWNTSDTG WAKSAWSSVF SPWIQGACVF THHLPRFEPT SILQTLSKYP I (1-320 aa encoded by BC002790)
靶标信息
Has medium-chain fatty acid:CoA ligase activity with broad substrate specificity (in vitro). Acts on acids from C(4) to C(11) and on the corresponding 3-hydroxy- and 2,3- or 3,4-unsaturated acids (in vitro).
仅用于科研。不用于诊断过程。未经明确授权不得转售。
生物信息学
蛋白别名: Acyl-CoA synthetase medium-chain family member 3; Acyl-coenzyme A synthetase ACSM3, mitochondrial; Butyrate--CoA ligase 3; butyryl coenzyme A synthetase 3; Butyryl-coenzyme A synthetase 3; Middle-chain acyl-CoA synthetase 3; Propionate--CoA ligase; Protein SA; Protein SA homolog; SA; SA (rat hypertension-associated) homolog; SA hypertension-associated homolog; SA rat hypertension-associated homolog; SA rat hypertension-associated protein; ssubA; unnamed protein product
基因别名: ACSM3; SA; SAH
UniProt ID: (Human) Q53FZ2, (Mouse) Q3UNX5, (Rat) Q6SKG1
Entrez Gene ID: (Human) 6296, (Mouse) 20216, (Rat) 24763